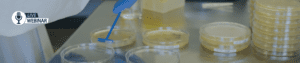

Cytotoxicity Testing
Home » Services » Microbiology Testing » Cytotoxicity Testing
Comprehensive Cytotoxicity ISO 10993-5 Testing
Cytotoxicity testing is essential for ensuring the safety and biocompatibility of medical devices. At Cormica, we adhere to ISO 10993-5 and USP 87 standards to provide reliable assessments. Our advanced methods evaluate the presence of cytotoxic effects, ensuring devices are safe for patient use.
We utilise two key testing methods: the Agar Diffusion Method and the Extraction/Elution Method. These techniques offer a thorough evaluation of various shapes and sizes of materials, from surgical scalpels to creams and liquids, delivering precise and trustworthy results.
Cytotoxicity Agar Diffusion Method
The Agar Diffusion Assay is indirect method that allow samples to be exposed to monolayer cells by adding a layer of agar which allows diffusion of leachable materials from the sample to the monolayer cells.
This test allows a qualitative assessment of cytotoxicity. This assay is not appropriate for leachables that cannot diffuse through the agar layer, or that may react with agar.
Examples of suitable materials for this method include:
- Transparent materials
- Contact lenses
- Liquids/ creams
The test plates are incubated alongside positive and negative controls in CO2 Incubator at 37±1°C for 24 hours up 25 hours.
The cytotoxicity is assessed by measuring the reactivity zone around and under the sample. As per ISO 10993-5:2009 the reactivity grade is listed:
Grade | Reactivity |
0 | None |
1 | Slight |
2 | Mild |
3 | Moderate |
4 | Severe |
The achievement of a numerical grade greater than 2 is considered as cytotoxic effect.
Testing by agar diffusion method
- Indirect method suitable for testing transparent materials.
- Examples of materials that can be tested include contact lenses or flat clear plastic.
- Liquid/cream material can be applied to a square of filter paper for testing.
- Cell monolayer is cushioned with an agar overlay, on which test and control articles are placed.
- Extractables from the sample will migrate through the agar layer to the cell monolayer.
- Any cytotoxicity will create visible disruption to the cell layer directly below the test article position.
Cytotoxicity Extraction / Elution Method
The extraction method is a qualitative test. The test is designed to determine the presence of extractable cytotoxic substances in medical devices . The test material is extracted in culture medium for 4 hours, 24 hours,48 hours or 72 hours depending on the duration of the patient contact. Serial dilutions are prepared and incubated for 24 hours.
As per ISO 10993-5:2009 the reactivity grade is listed:
Grade | Reactivity |
0 | None |
1 | Slight |
2 | Mild |
3 | Moderate |
4 | Severe |
The achievement of a numerical grade greater than 2 is considered as cytotoxic effect.
Testing by extraction method
- Suitable for most medical devices which may be tested as composite or individual components.
- Cell monolayers are directly exposed to test and control material by means of fluid extracts.
- Include morphological changes or appearance of cellular contents in test and control material.
- A change in appearance records a positive cytotoxic reaction.
Cytotoxicity Testing FAQ's
What is cytotoxicity testing?
In vitro test methods used to assess the cytotoxicity of medical devices, using mammalian cells.
How long does the cytotoxicity extraction process take?
This depends on the intended use of the device and patient contact time. Limited contact may require 4-24 hours, however, some devices may require an extended extraction process of 72 hours if in long term contact with the patient.
When should I look at Cytotoxicity testing?
ISO 10993-1 should be consulted to evaluate the testing requirement through a risk management process.